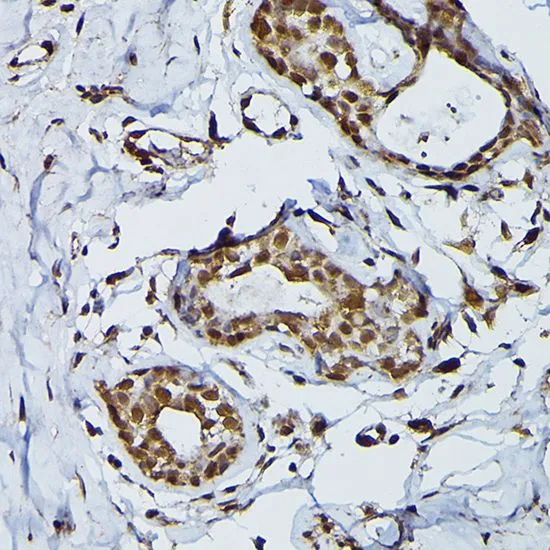

IHC-P analysis of mouse spleen tissue using GTX66476 PRPF4 antibody. Dilution : 1:200
PRPF4 antibody
GTX66476
ApplicationsWestern Blot, ImmunoHistoChemistry, ImmunoHistoChemistry Paraffin
Product group Antibodies
ReactivityHuman, Mouse, Rat
TargetPRPF4
Overview
- SupplierGeneTex
- Product NamePRPF4 antibody
- Delivery Days Customer9
- Application Supplier NoteWB: 1:500 - 1:2000. IHC-P: 1:50 - 1:200. *Optimal dilutions/concentrations should be determined by the researcher.Not tested in other applications.
- ApplicationsWestern Blot, ImmunoHistoChemistry, ImmunoHistoChemistry Paraffin
- CertificationResearch Use Only
- ClonalityPolyclonal
- ConjugateUnconjugated
- Gene ID9128
- Target namePRPF4
- Target descriptionpre-mRNA splicing tri-snRNP complex factor PRPF4
- Target synonymsHPRP4, HPRP4P, PRP4, Prp4p, RP70, SNRNP60, U4/U6 small nuclear ribonucleoprotein Prp4, PRP4 homolog, PRP4 pre-mRNA processing factor 4 homolog, PRP4/STK/WD splicing factor, U4/U6 snRNP 60 kDa protein, WD splicing factor Prp4, pre-mRNA processing factor 4
- HostRabbit
- IsotypeIgG
- Protein IDO43172
- Protein NameU4/U6 small nuclear ribonucleoprotein Prp4
- Scientific DescriptionThe protein encoded by this gene is part of a heteromeric complex that binds U4, U5, and U6 small nuclear RNAs and is involved in pre-mRNA splicing. The encoded protein also is a mitotic checkpoint protein and a regulator of chemoresistance in human ovarian cancer. Several transcript variants encoding different isoforms have been found for this gene. [provided by RefSeq, Apr 2016]
- ReactivityHuman, Mouse, Rat
- Storage Instruction-20°C or -80°C,2°C to 8°C
- UNSPSC12352203